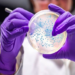
ஜப்பானில் பரவிவரும் பாக்டீரியா தொடர்பில் இலங்கையர்களுக்கான அறிவிப்பு!

நேற்றைய தினம் இரவு 11.02 மணியளவில் நிகழ்ந்த புவி நடுக்கத்தின் அளவு 2.3 ரிக்டர் என் தேசிய புவிச்சரிதவியல் மற்றும் கனிமவள பிரிவு அறிவித்துள்ளது.
இந்த புவி நடுக்கத்தின் குவிமையம் (Epic Centre) தாண்டிக்குளத்திற்கும் கூமாங்குளத்திற்கும் இடைப்பட்ட மரிக்காரம்பளையாகும்.
இந்த குவி மையம் புவிமேற்பரப்பிலிருந்து 10 கிலோமீற்றர் ஆழத்தில் நிகழ்ந்துள்ளது.
இந்த புவி நடுக்கத்தின் குவிமையம் மிகச் சரியாக இந்த பதிவில் இணைக்கப்பட்டுள்ள படத்தில் காட்டப்பட்டுள்ள வீட்டின் கீழேயே நிகழ்ந்துள்ளது.
இன்று காலை நான் இது தொடர்பாக இட்ட பதிவில் கருத்துரைத்த பலர் கல் அகழ்வுச் செயற்பாடுகள், மற்றும் குழாய்க்கிணறு தோண்டுதல் செயற்பாடுகள் காரணமாக இந்த நிலநடுக்கம் தோன்றியிருக்கலாம் என தெரிவித்தனர்.
ஆனால் புவி நிலநடுக்கத்திற்கும் இவைக்கும் எந்தவிதமான தொடர்பும் கிடையாது.
வவுனியாவில் நிகழ்ந்த புவிநிலநடுக்கம் 10 கிலோமீற்றர் ஆழத்தில் நிகழ்ந்துள்ளது. ஆனால் இந்த கல்லகழ்வு மற்றும் குழாய்க்கிணறுகள் புவி மேற்பரப்பில் இருந்து வெறுமனே 100 மீற்றருக்குள்ளேயே நிகழ்கின்றன.
இந்த கல்லகழ்வு மற்றும் குழாய்க்கிணறு தோண்டுதல் வேறுபல பிரச்சினைகளைத் தோற்றுவிக்கும். பொதுவாக எதிர்வு கூற முடியாத இயற்கை அனர்த்தங்களில் புவி நிலநடுக்கம் முதன்மையானது.
ஆனால் உலகின் பல பிரதேசங்களில் நிகழ்ந்த பாரிய புவி நிலநடுக்க நிகழ்வுகள் இரண்டாகவே நிகழ்ந்துள்ளன.
முதலாவது மிக மெதுவானதாக வெறும் நடுக்கத்துடன் கூடியதாகவே அமைந்துள்ளது. இதனை உணர்ந்து கட்டுமானங்களை விட்டு வெளியே வந்து வெளிப்பிரதேசங்களில் நின்றால் மிக மோசமான பாதிப்பை ஏற்படுத்தக்கூடிய இரண்டாவது புவி நடுக்கத்திலிருந்து எம்மைப் பாதுகாக்கலாம்.
இலங்கையில் அண்மைக்காலப் பகுதியில் இலங்கையின் கடற்பிராந்தியங்களிலும் நிலப்பகுதிகளிலும் சிறிய அளவிலான நிலநடுக்கங்கள் அதிக அளவில் ஏற்பட்டு வருகின்றன.
இவை எதிர்காலத்தில் மிகப்பெரிய அளவிலும் நிலநடுக்கங்கள் இடம்பெறலாம் என்பதற்கான சமிக்ஞைகளாகவே கருதலாம்.
அனர்த்தங்கள் தொடர்பான விழிப்புணர்வை இலங்கையின் சகல பிரஜைகளுக்கும் வழங்க வேண்டும்.
குறிப்பாக வெள்ளப்பெருக்கு, வரட்சி, புயல், சூறாவளி, நிலச்சரிவு, புவிநடுக்கம் தொடர்பான இயற்கை அனர்த்தங்கள் பற்றியும் வீதி விபத்துக்கள் மற்றும் தீ விபத்துக்கள் பற்றியும் இலங்கையின் அனைத்து மக்களுக்கும் விழிப்புணர்வை ஏற்படுத்துவதன் மூலம் இவற்றினால் ஏற்படும் உயிர் மற்றும் உடமை இழப்புக்களை தவிர்க்க முடியுமென யாழ்ப்பாண பல்கலைக்கழக புவியியற்துறை மூத்த விரிவுரையாளர் நாகமுத்து பிரதீபராஜா தெரிவித்துள்ளார்.